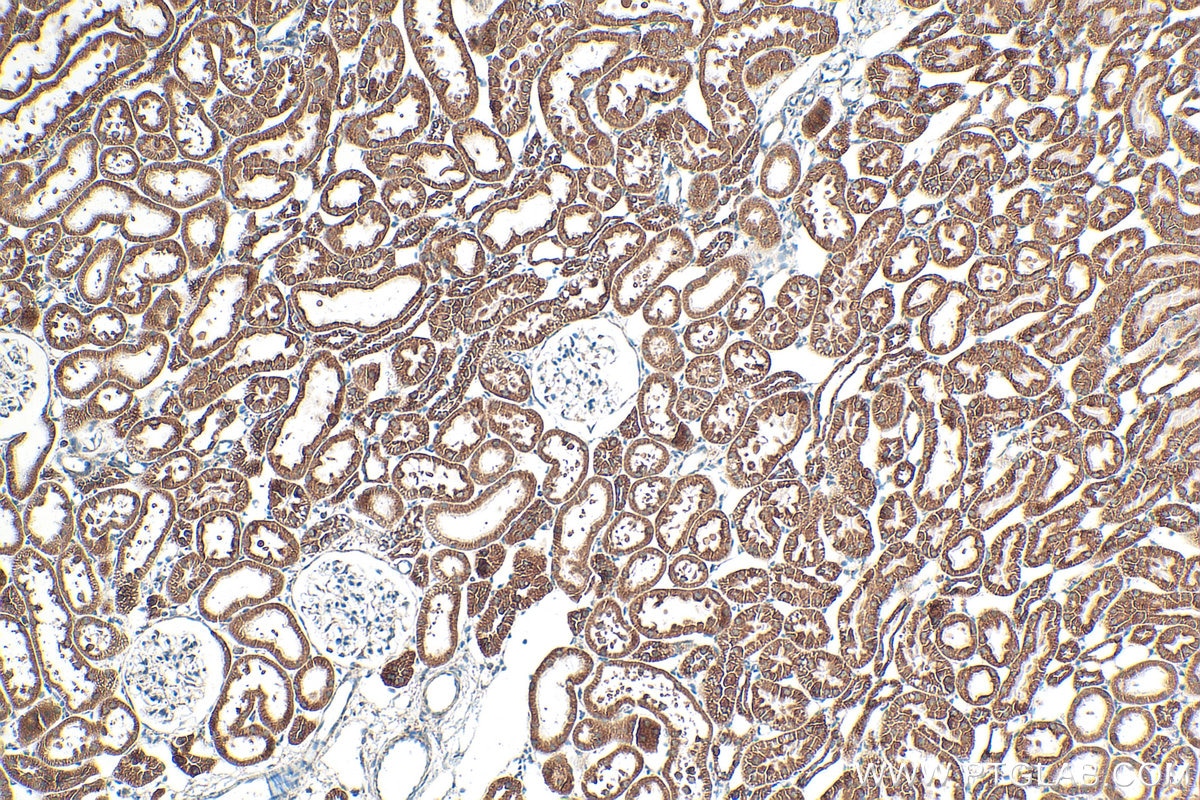
Immunohistochemistry (IHC) staining of rat kidney tissue using TIMM8A Polyclonal antibody (11179-1-AP)
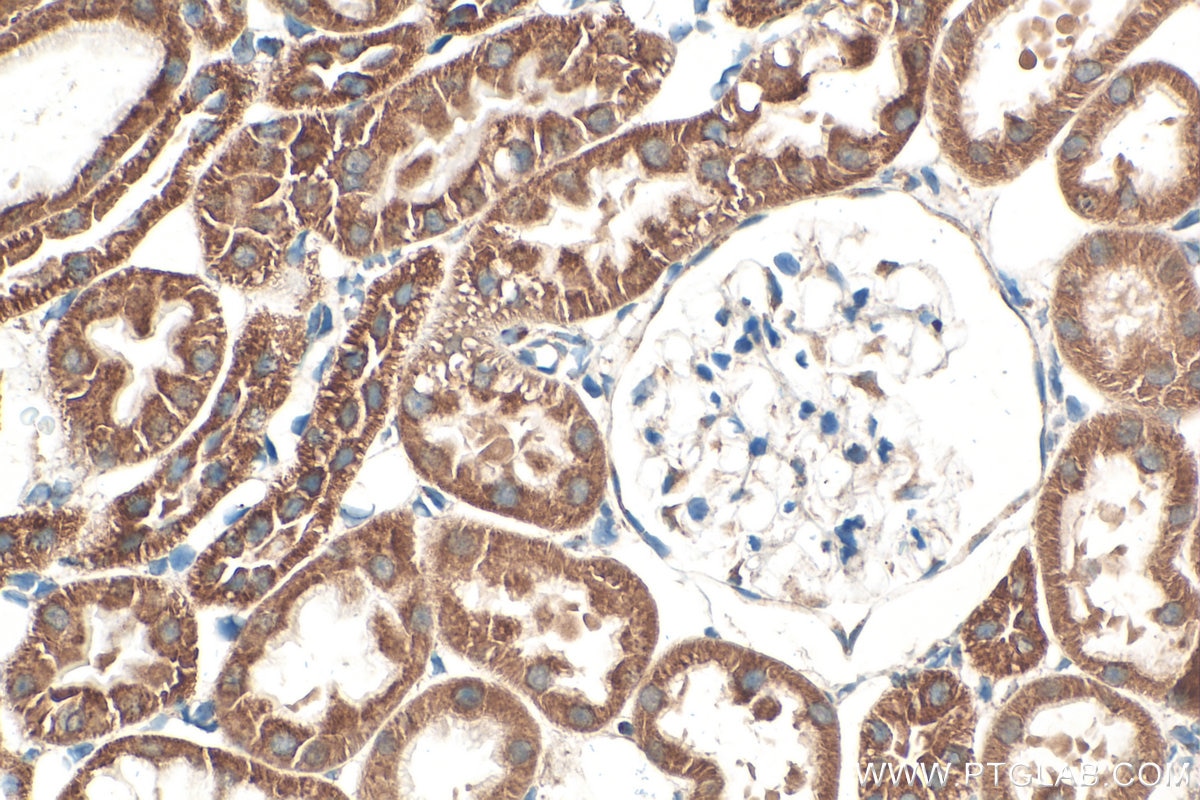
Immunohistochemistry (IHC) staining of rat kidney tissue using TIMM8A Polyclonal antibody (11179-1-AP)

Tested Applications
| Positive WB detected in | mouse testis tissue, rat testis tissue |
| Positive IP detected in | mouse testis tissue |
| Positive IHC detected in | human intrahepatic cholangiocarcinoma tissue, human stomach cancer tissue, rat kidney tissue Note: suggested antigen retrieval with TE buffer pH 9.0; (*) Alternatively, antigen retrieval may be performed with citrate buffer pH 6.0 |
| Positive IF/ICC detected in | HeLa cells |
Recommended dilution
| Application | Dilution |
|---|---|
| Western Blot (WB) | WB : 1:500-1:3000 |
| Immunoprecipitation (IP) | IP : 0.5-4.0 ug for 1.0-3.0 mg of total protein lysate |
| Immunohistochemistry (IHC) | IHC : 1:200-1:800 |
| Immunofluorescence (IF)/ICC | IF/ICC : 1:50-1:500 |
| It is recommended that this reagent should be titrated in each testing system to obtain optimal results. | |
| Sample-dependent, Check data in validation data gallery. | |
Published Applications
| KD/KO | See 2 publications below |
| WB | See 6 publications below |
| IF | See 1 publications below |
Product Information
11179-1-AP targets TIMM8A in WB, IHC, IF/ICC, IP, ELISA applications and shows reactivity with human, mouse, rat samples.
| Tested Reactivity | human, mouse, rat |
| Cited Reactivity | human, mouse |
| Host / Isotype | Rabbit / IgG |
| Class | Polyclonal |
| Type | Antibody |
| Immunogen |
CatNo: Ag1661 Product name: Recombinant human TIMM8A protein Source: e coli.-derived, PGEX-4T Tag: GST Domain: 1-97 aa of BC015093 Sequence: MDSSSSSSAAGLGAVDPQLQHFIEVETQKQRFQQLVHQMTELCWEKCMDKPGPKLDSRAEACFVNCVERFIDTSQFILNRLEQTQKSKPVFSESLSD Predict reactive species |
| Full Name | translocase of inner mitochondrial membrane 8 homolog A (yeast) |
| Calculated Molecular Weight | 11 kDa |
| Observed Molecular Weight | 11 kDa |
| GenBank Accession Number | BC015093 |
| Gene Symbol | TIMM8A |
| Gene ID (NCBI) | 1678 |
| RRID | AB_2204687 |
| Conjugate | Unconjugated |
| Form | Liquid |
| Purification Method | Antigen affinity purification |
| UNIPROT ID | O60220 |
| Storage Buffer | PBS with 0.02% sodium azide and 50% glycerol, pH 7.3. |
| Storage Conditions | Store at -20°C. Stable for one year after shipment. Aliquoting is unnecessary for -20oC storage. 20ul sizes contain 0.1% BSA. |
Background Information
TIMM8A (translocase of inner mitochondrial membrane 8A) is a mitochondrial intermembrane space chaperone that forms a 70 kDa hetero-hexamer with TIMM13 and escorts hydrophobic inner-membrane proteins from the cytosol into mitochondria. It acts as a chaperone-like protein that protects the hydrophobic precursors from aggregation and guide them through the mitochondrial intermembrane space. The TIMM8-TIMM13 complex mediates the import of proteins such as TIMM23, SLC25A12/ARALAR1 and SLC25A13/ARALAR2, while the predominant TIMM9-TIMM10 70 kDa complex mediates the import of much more proteins. Probably necessary for normal neurologic development. (PMID: 11489896; 15254020)
Protocols
| Product Specific Protocols | |
|---|---|
| IF protocol for TIMM8A antibody 11179-1-AP | Download protocol |
| IHC protocol for TIMM8A antibody 11179-1-AP | Download protocol |
| IP protocol for TIMM8A antibody 11179-1-AP | Download protocol |
| WB protocol for TIMM8A antibody 11179-1-AP | Download protocol |
| Standard Protocols | |
|---|---|
| Click here to view our Standard Protocols |
Publications
| Species | Application | Title |
|---|---|---|
Cell Death Dis CHCHD2 rescues the mitochondrial dysfunction in iPSC-derived neurons from patient with Mohr-Tranebjaerg syndrome
| ||
Elife Function of hTim8a in complex IV assembly in neuronal cells provides insight into pathomechanism underlying Mohr-Tranebjærg syndrome.
| ||
Cell Death Dis Haploinsufficiency in the mitochondrial protein CHCHD4 reduces brain injury in a mouse model of neonatal hypoxia-ischemia. | ||
Mol Genet Genomic Med Functional analysis of a novel mutation in the TIMM8A gene that causes deafness-dystonia-optic neuronopathy syndrome. |